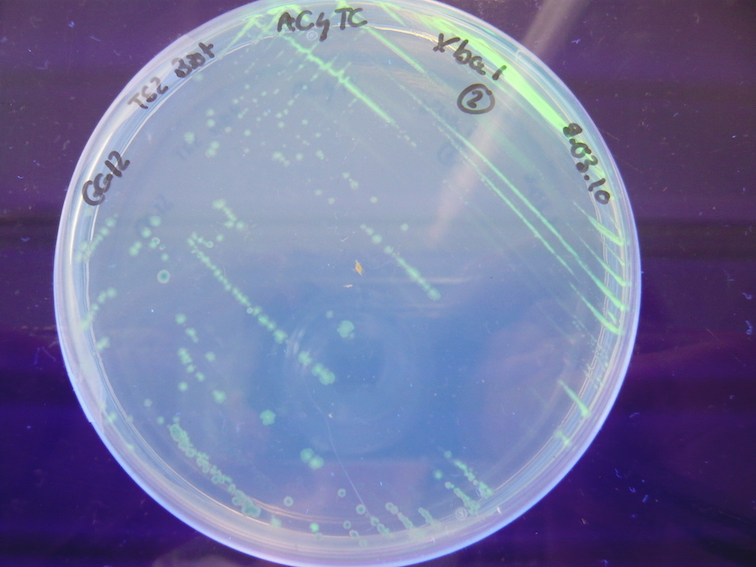
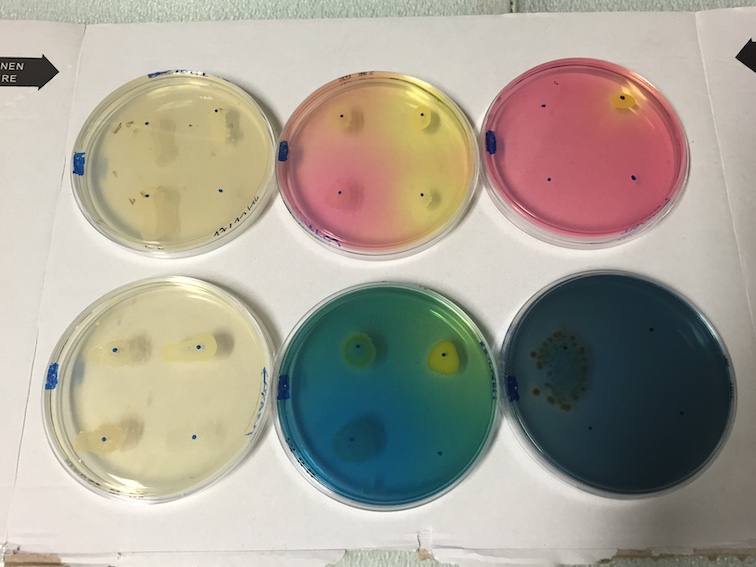

BTS Biotechnologie en recherche et en production
Le BTS des métiers de la recherche et de la production en biotechnologie
- Contenu de la formation
La formation au lycée, d'une durée de 2 ans, est axée autour de l’acquisition des compétences technologiques et transversales nécessaires aux activités professionnelles.
Deux stages en laboratoire de recherche ou de bioproduction d'une durée de 16 semaines au total, complétent la formation et sont l'occasion de mettre en pratique les compétences professionnnelles. Au cours des stages, les étudiants sont intégrés dans l’équipe et participent à son activité sous la responsabilité du professionnel tuteur de stage.
Compétences technologiques
- Mise en œuvre de techniques de biotechnologie moléculaire :
chromatographies, électrophorèses, spectrophotométrie, extractions, purifications, PCR, blots
- Mise en œuvre de techniques de biotechnologie cellulaire :
croissance bactérienne, culture de cellules eucaryotes, dénombrement, marquage, préparation de milieux de culture
- Mise en œuvre d’une production de molécule d'intérêt pharmaceutique par procédé biotechnologique en respectant les bonnes pratiques de fabrication
- Traçabilité des informations utiles aux activités (cahier de laboratoire, fiche de fabrication)
- Exploitation des résultats et des données expérimentales
- Contribution à la conception et à l’adaptation des expérimentations et/ou de la productionCompétences transversales
- Participation au fonctionnement du laboratoire :
gestion des stocks, des inventaires et des commandes, exploitation de documents techniques, analyse et prévention des risques
- Développement de l'autonomie, de l'esprit d'équipe, de l’engagement dans les projets
- Communication à l’oral en français ou en anglais avec divers interlocuteurs (techniciens, supérieurs hiérarchiques, technicocommerciaux…)
- Rédaction de documents professionnels
- Développement de l’intégrité scientifique et questionnement éthique - Organisation des enseignements
- Épreuves de l'examen
- Parcours post BTS
- Métier de technicien en biotechnologie
- Domaines d'activité
- Pourquoi à l'ENCPB ?